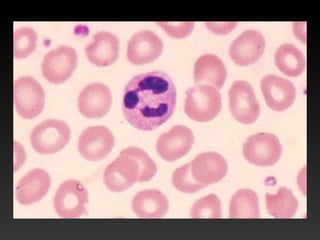
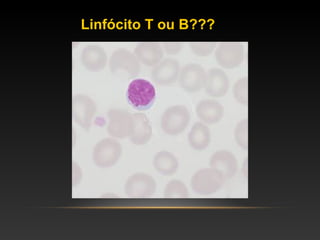
Linfócito T ou B???

O documento discute as principais células do sistema imunológico, incluindo granulócitos, células mononucleares, células dendríticas, linfócitos e células NK. Todas essas células originam-se da medula óssea e desempenham papéis importantes tanto na resposta imune inata quanto na resposta adaptativa ou específica.